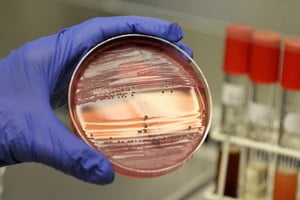

Бруцеллез симптомы у человека, профилактика и лечение
Бруцеллез — зоонозная инфекционная болезнь, которую переносят животные. Несмотря на то, что носителями инфекции является домашний скот, она крайне заразна для человека.
Для недуга характерно длительное и тяжелое течение, инфекция поражает опорно-двигательный аппарат, сердце, сосуды, центральную нервную систему. Очень важно своевременно обнаружить симптомы бруцеллеза, опытный врач без труда распознает их при первом обследовании.
Что это такое?
Бруцеллез — это зоонозное инфекционное заболевание, вызываемое патогенными микроорганизмами из семейства бруцелл, и характеризующееся вялотекущим воспалительным процессом во всех органах и тканях с преимущественным поражением лимфатической, костно-суставной и нервной систем.
Врачи отмечают, что бруцеллез у человека представляет собой серьезную инфекционную болезнь, вызванную бактериями рода Brucella. Основные пути передачи инфекции — контакт с зараженными животными или употребление непастеризованных молочных продуктов. Симптомы заболевания могут быть разнообразными: от лихорадки и потливости до болей в мышцах и суставах. Врачи подчеркивают важность ранней диагностики и лечения, так как хроническая форма болезни может привести к серьезным осложнениям, включая поражение суставов и нервной системы. Профилактика остается ключевым аспектом борьбы с бруцеллезом, и специалисты рекомендуют соблюдать меры предосторожности при работе с животными и выбирать безопасные продукты. Важно также проводить вакцинацию животных, чтобы снизить риск передачи инфекции человеку.
https://youtube.com/watch?v=aIUpRflVdG0
Возбудитель
Возбудители бруцеллеза — неподвижные грамотрицательные бактерии, способные паразитировать внутриклеточно. Известно 6 типов возбудителей бруцеллеза и 17 биоваров.
Источником опасных для человека бруцелл являются главным образом 4 типа: козы, овцы (Br.melitensis), коровы (Br.abortus bovis), свиньи (Br.abortus suis) и собаки (Br.canis), выделяющие возбудителя с молоком, мочой, околоплодными водами, более того, переносчиком бруцеллёза является Жигалка осенняя (Stomaxys calcitrans).
Заражение человека происходит при непосредственном контакте с животными-носителями или при употреблении в пищу заражённых продуктов, — сырого молока, сыра, изготовленного из непастеризованного молока.
Симптомы бруцеллеза
На раннем этапе бруцеллез у человека, симптомы которого очень схожи с гриппом или другими вирусными инфекциями, очень сложно диагностировать. К начальным проявлениям бруцеллеза относятся:
- Повышение температуры с высокими «свечками» в дневное и вечернее время (наиболее распространенный признак бруцеллеза);
- Боль в спине, боль или жжение в конечностях;
- Плохой аппетит и снижение веса;
- Головная боль, ночной пот, слабость.
После проникновения в организм возбудителя, вызывающего бруцеллез, симптомы у человека проявляются через 5 — 30 дней (в среднем, 2-3 недели), при латентном носительстве может удлиняться до 3 месяцев. Тяжесть течения зависит от типа возбудителя:
- B. abortus вызывает слабо выраженные проявления. Состояние больного расценивается как легкое или средней степени тяжести, но заболевание чаще принимает хронический характер.
- Симптомы заболевания, вызванного B. canis могут иметь преходящий характер. Течение похоже на инфекцию, вызванную B. abortus, но чаще отмечается рвота и диарея.
- B. suis может вызывать формирование абсцессов в различных органах.
- B. melitensis вызывает тяжелое течение с внезапным началом. Такое заболевание может привести к инвалидности больного.
Затяжное (хроническое) течение бруцеллеза проявляется постоянной, нарастающей слабостью, апатией, болью в суставах. Такой характер имеет менее благоприятный прогноз и может привести к недооценке состояния и позднему обращению за медицинской помощью. Согласно статистическим данным, хроническое течение в несколько раз чаще оканчивается инвалидностью пациентов.
Бруцеллез — это инфекционное заболевание, вызываемое бактериями рода Brucella, которое передается от животных к человеку. Люди, столкнувшиеся с этой болезнью, часто делятся своими переживаниями и симптомами. Многие отмечают, что заболевание проявляется в виде высокой температуры, потливости, слабости и болей в мышцах. Некоторые пациенты рассказывают о долгих поисках правильного диагноза, так как симптомы могут быть схожи с другими заболеваниями.
Обсуждая лечение, многие подчеркивают важность ранней диагностики и назначения антибиотиков. Однако некоторые пациенты сталкиваются с рецидивами, что вызывает беспокойство и необходимость в длительном наблюдении. В социальных сетях можно встретить советы по профилактике, такие как избегание сырого молока и недостаточно термически обработанного мяса. В целом, опыт людей с бруцеллезом подчеркивает важность осведомленности о заболевании и его последствиях.
https://youtube.com/watch?v=NOSK_-B2rhY
Острая форма
Острая форма бруцеллеза устанавливается у больных, клинические симптомы у которых проявляются в течение 3-х месяцев.
При постепенном начале заболевания (чаще у пожилых больных) слабость, недомогание, разбитость, плохой сон, мышечные и суставные боли, субфебрильная температура тела — основные симптомы бруцеллеза в этот период. Периферические лимфоузлы увеличены незначительно (микрополиаденопатия). При нарастании симптомов интоксикации температура тела повышается значительно. У больного отмечаются проливные поты и ознобы. Увеличиваются печень и селезенка.
При быстром развитии заболевания (острый бруцеллез) температура тела повышается до 39 — 40°С. Температурная кривая имеет волнообразную форму, часто неправильного типа. У больного отмечаются проливные поты и ознобы, но общее самочувствие при этом остается удовлетворительным. Периферические лимфоузлы увеличены, некоторые из них болезненны при пальпации. Под кожей пальпируются болезненные образования — целлюлиты и фиброзиты. К концу первой недели увеличивается печень и селезенка. Очаговые поражения отсутствуют. СОЭ и лейкоциты остаются в пределах нормы либо незначительно повышены.
Подострая форма
Подострая форма бруцеллеза устанавливается у больных, клинические симптомы у которых проявляются в течение 3 — 6 месяцев. Заболевание характеризуется рецидивирующим течением. Температура тела беспокоит больного по нескольку дней. Мышечные и косно-суставные боли, парестезии, плохой сон и аппетит, мышечная слабость — основные симптомы бруцеллеза в этот период. На кожных покровах отмечаются аллергические проявления в виде экзантем и дерматитов.
В отдельных случаях при тяжелом течении заболевания обнаруживаются признаки инфекционно-аллергического эндокардита, миокардита и перикардита, признаки вялотекущего менингита. В 10 — 15% развивается клиническая картина поражения опорно-двигательного аппарата, периферической нервной системы и половой сферы.
https://youtube.com/watch?v=iJm0e5QrHMw
Хроническая форма
Для хронического течения бруцеллеза характерны периоды обострения и последующей ремиссии. Основной удар приходится по нервной системе: отмечаются различные нарушения слуха, зрения, снижение чувствительности, гипергидроз.
Страдает также опорно-двигательный аппарат. Могут развиться различные деструкции и деформации позвоночника, периостит, перихондрит, неврозы. Поражается и мочеполовая система: у женщин это проявляется в виде эндометрита, дисменореи, сальпингита, а у мужчин в основном развивается орхит.
Бруцеллез может становиться причиной ряда других патологических изменений: гормональных сбоев, артрозов, контрактуры, анкилозов.
Диагностика бруцеллеза
Обязательной считается лабораторная диагностика заболевания, включающая посевы спинномозговой жидкости, крови и пунктатов лимфатических узлов. Такую диагностику проводят в специальных лабораториях, поскольку из-за низкой высеиваемости выявить возбудителя инфекции очень сложно.
В последние годы распространение получили:
- реакция агрегатгемагглютинации, обнаруживающая антигены бруцелл в крови;
- реакция Кумбса, для выявления неполных антител при хроническом бруцеллезе;
- реакция Райта, наиболее информативная при остром бруцеллезе;
- реакцию лизиса бруцелл;
- проба Бюрне, с внутрикожным введением бруцеллина.
Диагностика заболевания заключается в дифференцировании заболевания от иных, сопровождающихся длительной лихорадкой, болезней. При остром бруцеллезе график измерения температуры имеет неправильный характер, с появлением озноба, повышенным потоотделением. Также врач должен исключить ревматоидный артрит и ревматизм, туберкулезные очаговые поражения, гонорейные и сифилитические артриты. При подозрении на бруцеллез проверяют состояние лимфоузлов, печени и селезенки.
Лечение бруцеллеза у человека
Этиотропная терапия проводится путем применения антибиотиков. Важно соблюдать некоторые правила:
- Одновременное использование двух препаратов, активных в отношении бруцелл;
- Оптимальная длительность не менее 5-6 недель;
- Непрерывность;
- Назначение антибиотиков только в при обострении процесса. Применение антибиотика в межприступном периоде принесет больше вреда, чем пользы;
- Использование высоких дозировок.
Из конкретных лечебных схем неплохо проявили себя комбинации:
- Тетрациклина с стрептомицином;
- Рифампицина с доксициклином;
- Доксициклина с стрептомицином или эритромицином;
- Азитромицина или кларитромицина с бисептолом;
- Доксициклина с амикацином.
В связи с внутриклеточным паразитированием бруцелл в человеческом организме и длительным течением болезни лечение должно быть также продолжительным. Главными его компонентами должны стать этиотропный (уничтожение возбудителя), патогенетический (воздействие на механизмы запуска и поддержания воспалительного процесса), симптоматический (ликвидация тревожных симптомов).
Осложнения
Бруцеллез может привести к поражению почти любой части тела больного, включая органы репродуктивной системы, печень, сердце и центральную нервную систему.
Среди возможных осложнений отмечают:
- Бруцеллез у беременных может стать причиной невынашивания, аномалий развития плода.
- Артрит. Инфекционное воспаление суставов характеризуется болью, скованностью движений и отеком в области поражения (обычно — в коленях, лодыжках, тазобедренном суставе, на запястьях и в позвоночнике);
- Эндокардит. Это одно из самых серьезных состояний, которое способно привести к нарушению работы сердечных клапанов. Эндокардит — основная причина смерти больных бруцеллезом;
- Инфекции центральной нервной системы: менингит (воспаление оболочек, окружающих головной мозг) и энцефалит (собственно воспаление головного мозга);
- Инфекционное воспаление печени и селезенки. При развитии данного осложнения у больного отмечается увеличение этих органов в размере и появляются болевые ощущения в области эпигастрия;
- Инфекционное воспаление яичек (эпидидимо-орхит). Бруцеллы могут проникать в эпидидимис, трубку, соединяющую семявыносящие протоки и яички. Оттуда инфекция может распространяться дальше в яички, вызывая отек и боль.
Прогноз лечения
Бруцеллёз редко становится причиной смерти. Даже до появления антибиотиков смертность при нём не превышала 2 % и была в основном обусловлена эндокардитом. Однако бруцеллёз нередко заканчивается инвалидностью. Тяжесть остаточных дефектов зависит от вида возбудителя.
Самые тяжёлые последствия оставляет бруцеллёз, вызванный Brucella melitensis. Одна из причин инвалидности — неврологические расстройства, в том числе поражение спинного мозга и параплегия. Описана нейросенсорная тугоухость как осложнение менингоэнцефалита и лечения стрептомицином.
Профилактика
Если имеются риски заболевания данным недугом, то при ситуации, когда возникают некоторые признаки бруцеллеза необходимо незамедлительно обратиться к специалисту. Все профилактические меры могут быть направлены на предотвращение контактов с больными животными, если это не представляется возможным, то нужно в обязательном порядке проводить меры для того, чтобы предотвратить заболевание животных.
Вопрос-ответ
Каковы основные симптомы бруцеллеза у человека?
Симптомы бруцеллеза могут варьироваться, но наиболее распространенные включают лихорадку, потливость, усталость, головные боли, мышечные и суставные боли. У некоторых пациентов могут наблюдаться более серьезные осложнения, такие как инфекции органов, если заболевание не лечить.
Как происходит заражение бруцеллезом?
Заражение бруцеллезом обычно происходит через контакт с инфицированными животными, их продуктами или через употребление непастеризованного молока и молочных продуктов. Также возможно заражение через вдыхание аэрозолей, содержащих бактерии.
Как лечится бруцеллез у человека?
Лечение бруцеллеза обычно включает курс антибиотиков, таких как доксициклин и рифампицин, которые принимаются в течение нескольких недель. Важно начать лечение как можно раньше, чтобы предотвратить осложнения и улучшить прогноз.
Советы
СОВЕТ №1
Избегайте употребления непастеризованного молока и молочных продуктов, так как они могут быть источником инфекции. Всегда проверяйте, что молоко прошло пастеризацию, чтобы снизить риск заражения бруцеллезом.
СОВЕТ №2
При работе с животными, особенно с крупным рогатым скотом, соблюдайте меры предосторожности: используйте защитные перчатки и маски, а также регулярно проводите вакцинацию животных, чтобы предотвратить распространение инфекции.
СОВЕТ №3
Если вы планируете путешествие в регионы, где бруцеллез распространен, будьте осторожны и избегайте контакта с дикими и домашними животными. Также старайтесь не употреблять местные продукты, которые могут быть небезопасными.
СОВЕТ №4
Регулярно проходите медицинские обследования, особенно если вы работаете в сельском хозяйстве или в лабораториях, связанных с животными. Раннее выявление симптомов бруцеллеза может значительно облегчить лечение и предотвратить осложнения.